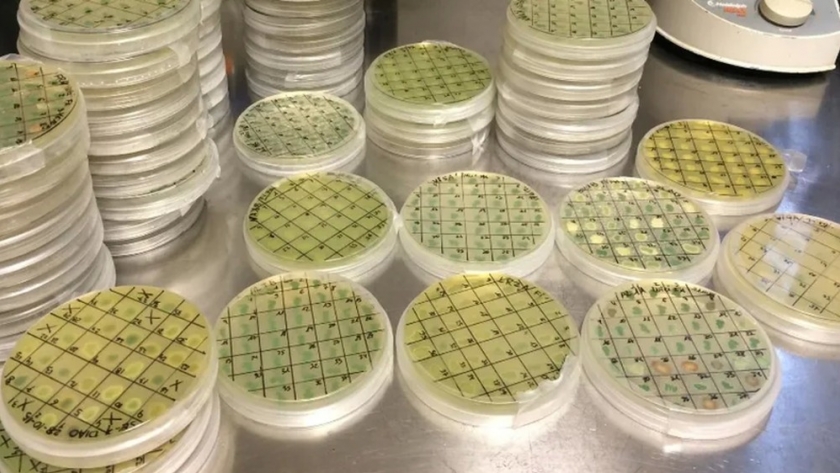
Instalan una planta de producción de levaduras nativas para vinos

La Universidad Nacional del Comahue (UnCo), junto a la empresa Patagonia Beverage SRL, comenzó la construcción de una planta de levaduras nativas a base de bagazo de manzana en Villa Regina, que estará destinada a abastecer la producción de vinos en la región. "El bagazo es lo que utilizamos como alimento para propagar las células de levaduras para vinos que seleccionamos en la UnCo", explicó la directora del proyecto, Adriana Catalina Caballero.
El gobierno provincial informó que el proyecto fue denominado "De Río Negro al país: producción de levaduras para la vinificación" e integra una de las diez iniciativas seleccionadas por la Agencia RN Innova, tras la convocatoria del "Programa de Proyectos Federales de Innovación 2022 (PFI) del Ministerio de Ciencia, Tecnología e Innovación de Nación".
El objetivo del proyecto es realizar a escala industrial el proceso de propagación de células de levaduras nativas de la Patagonia, Saccharomyces y non-Saccharomyces seleccionadas por sus propiedades enológicas, utilizando como sustrato un medio en base a bagazo de manzana (EBM).
Con la primera parte del desembolso del Aporte No Reembolsable (ANR) recibido por PFI 2022, se avanzó en la primera etapa del proyecto con la construcción de la planta de tratamiento de efluentes líquidos y también con la adquisición y montaje de equipamiento.
De ese modo se completó la maquinaria de la línea de producción industrial de levaduras nativas en la forma seca y activa (LSA) y se avanzó en la instalación de los servicios eléctricos y de la línea de vapor.
La investigadora dijo que la línea de producción comprende la "propagación en un tanque de fermentación, luego se prensa, se mezcla con elementos inertes y se seca para obtener levadura activa"
Una vez que entre en producción la planta rionegrina, la levadura será dispuesta en envases de medio y un kilo. Para la vinificación se utilizan unos 20 gramos de levadura seca por cada 100 hectolitros, "o sea que al momento de la vinificación se necesita una gran cantidad de masa de levadura, esa es la mejor manera de que esté dispuesta para el bodeguero en esos momentos", apuntó.
Caballero dijo que, "se trata de una pyme que creció mucho, esto les va permitir desarrollar otra línea y valorizar el bagazo".
Remarcó que el precio de la levadura importada "es caro, la idea es beneficiar a los bodegueros porque el precio de este producto será mucho más bajo que el que puede costar en una importación".
Afirmó que se está terminando con las conexiones de la línea de producción y que ya se compró la envasadora para la levadura.
"La idea es formar parte de la economía circular, no generar pasivos ambientales con la recuperación del bagazo poniéndolo en valor y realizar todo el tratamiento adecuado a los desechos que se puedan producir".
Toda la evaluación de la producción ya fue realizada en escala piloto, con resultados positivos, ahora queda hacer el escalado industrial. El objetivo es escalar 15 litros a 1.250 litros de caldo de cultivo.
"Esto permite agregar valor a la vitivinicultura rionegrina, leva dar características distintivas del "terroir", una tendencia que se profundiza cada vez más en el mundo actual", aseguró la académica.
Caballero explicó que hasta los años 60 la vinificación se realizaba de manera natural, con las levaduras que crecían en las superficies de las uvas.
Por esa época, con la intención de controlar la calidad y corregir la variabilidad de años entre los vinos, las empresas multinacionales comenzaron la producción de levaduras seleccionadas en otros terruños vitivinícolas del mundo, y la primera que se realizó fue en California.
"Nosotros evaluamos todo el procedimiento, las condiciones de propagación, de extrusado de secado para que estén vivas y vitales, que conserven esa propiedad fermentativa que es transformar el azúcar de la uva en vino", detalló la especialista.
Más Producción Neuquén
